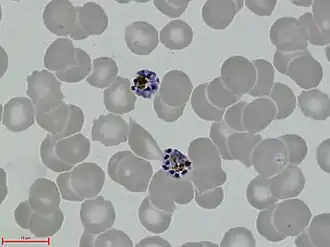
alternativní popis obrázku chybí

Plasmodium vivax
![]() Plasmodium vivax - schizont | |
| Vědecká klasifikace | |
| Doména | Eukaryota |
| Podříše | SAR |
| Infraříše | Alvelata |
| Kmen | výtrusovci (Apicomplexa) |
| Třída | krvinkovky (Haematozoea) |
| Řád | Haemosporida |
| Čeleď | Plasmodiidae |
| Rod | Plasmodium |
| Binomické jméno | |
| Plasmodium vivax Grassi a Raimondo Feletti; 1890 | |
| Některá data mohou pocházet z datové položky. | |
Plasmodium vivax je jednobuněčný parazitický prvok z rodu Plasmodium. Patří mezi pět druhů způsobujících malárii u lidí. Tento druh je považován za nejrozšířenějšího původce malárie mimo Afriku a je známý svou schopností přetrvávat v játrech hostitele ve formě hypnozoitů, což může vést k relapsům onemocnění i dlouho po primární infekci. Infekce P. vivax je méně smrtelná než infekce Plasmodium falciparum, přesto může způsobovat závažné zdravotní komplikace a má veliký ekonomický dopad.[1]
Životní cyklus[2]

Životní cyklus Plasmodium vivax zahrnuje dva hostitele, člověka a komára rodu Anopheles. Člověk je mezihostitelem a Anopheles je definitivním hostitelem, protože v něm dochází k pohlavnímu rozmnožování parazita.
Přenos a jaterní fáze (jaterní schizogonie)
K infekci dochází při kousnutí infikovaným komárem, který ve svých slinách přenese sporozoity do krevního oběhu člověka. Sporozoiti rychle pronikají do jaterních buněk, kde se vyvíjejí do schizontů a produkují tisíce merozoitů. Někteří však zůstávají v játrech jako hypnozoiti, kteří mohou po týdnech až letech reaktivovat infekci.[2]
Erytrocytární fáze (erytrocytární schizogonie)
Merozoiti se uvolňují do krevního oběhu a napadají mladé červené krvinky (retikulocyty). K proniknutí do retikulocytů využívají Duffy antigen, který se přirozeně vyskytuje na povrchu červených krvinek. V retikulocytech procházejí merozoiti vývojem přes „prstýnek“ a trofozoity až po schizonty, kteří uvolní další merozoity. Merozoiti se uvolňují prasknutím červené krvinky, která je v tuto fázi až dvakrát větší než normálně. Napadené krvinky praskají synchronizovaně každých 48 hodin, což způsobuje tzv. malarickou horečku. Někteří merozoiti se v retikulocytech vyvinou v gametocyty, které jsou klíčové pro přenos na komára.
Přenos na komára
Pokud komár nasaje krev obsahující gametocyty, ty se ve střevě komára dále vyvíjejí, splynou v zygotu a vytvářejí pohyblivou ookinetu. Ta proniká do stěny střeva, kde se vyvine v oocystu, produkující nové sporozoity. Tito sporozoiti se dostanou do slinných žláz komára a mohou infikovat dalšího hostitele.
Význam Duffy antigenu
P. vivax dokáže infikovat červené krvinky, protože má tzv. Duffy vazebný protein (Duffy binding protein). Tím rozpozná Duffy antigen na povrchu červených krvinek a může do nich proniknout. V západní Africe je rozšířena Duffy-negativní mutace (Duffy antigen je nefunkční, nedochází k vazbě Duffy vazebného proteinu). Nositelé této mutace jsou imunní vůči infekci P. vivax, a proto je infekce v Africké populaci méně častá.[3]
Recentní studie ukázaly, že P. vivax v některých oblastech dokáže napadat i Duffy-negativní červené krvinky a způsobit infekci u lidí s Duffy-negativní mutací. Jedná se nejspíše o novou adaptaci parazita, který tak není plně závislý na přítomnosti Duffy antigenu u červených krvinek.[4]
Patologie
Infekce P. vivax způsobuje malárii, která se projevuje opakujícími se horečkami (typicky každých 48 hodin), anémií způsobenou destrukcí červených krvinek, zvětšením sleziny (splenomegalie), únavou a slabostí.
Ačkoli P. vivax obvykle nezpůsobuje smrtelné komplikace jako P. falciparum, může vést k těžkým formám malárie, včetně postižení mozku, poškození orgánů a vážné anémie.
Léčba a prevence
Léčba[5]
K léčba infekce Plasmodium vivax se využívají:
- Chlorochin – používaný k odstranění parazitů v krvi
- Primaquin nebo tafenoquin – nutné k eradikaci hypnozoitů v játrech a prevenci relapsů
- V oblastech s rezistencí na chlorochin se používají kombinace jako artesunát + mefloquin
Před nasazením primaquinu nebo tafenoquinu je nutné otestovat pacienty na deficit enzymu glukóza-6-fosfát dehydrogenázy (G6PD), protože u těchto jedinců mohou tyto léky způsobit hemolytickou anémii.
Prevence[1]
Prevence infekce Plasmodium vivax zahrnuje:
- Použití moskytiér a repelentů k ochraně před kousnutím komáry
- Insekticidy a opatření ke snížení populace komárů
- Chemoprofylaxe pro osoby cestující do endemických oblastí
- Vývoj vakcín, které by mohly poskytnout dlouhodobou ochranu proti infekci
Geografické rozšíření[1]
Plasmodium vivax se vyskytuje převážně v:
- Asii (Indie, Indonésie, Pákistán, Čína, Myanmar, Filipíny)
- Latinské Americe (Brazílie, Kolumbie, Peru, Venezuela)
- Africe (především na Madagaskaru a v některých oblastech Etiopie)
- Tichomořských ostrovech
V některých oblastech, zejména v jihovýchodní Asii a Jižní Americe, se objevují rezistentní kmeny, což komplikuje léčbu.
Původ
Dlouho se předpokládalo, že P. vivax pochází z jihovýchodní Asie. Genetické studie však ukázaly, že pochází z Afriky. Díky rozšíření mutace, která způsobuje nefunkčnost Duffy faktoru, byly infekce P. vivax v Africe výrazně potlačeny a parazit se rozšířil hlavně do Asie a Jižní Ameriky. P. vivax se nejspíše vyvinul z kmene parazitů, kteří infikovali šimpanze, gorily a lidi v Africe.[6]
Reference
- ↑ a b c ADAMS, John H.; MUELLER, Ivo. The Biology of Plasmodium vivax. Cold Spring Harbor Perspectives in Medicine. 2017-09, roč. 7, čís. 9, s. a025585. Dostupné online [cit. 2025-02-02]. ISSN 2157-1422. doi:10.1101/cshperspect.a025585. PMID 28490540. (anglicky)
- ↑ a b NEUPANE, Laxmi. Plasmodium vivax- Life Cycle in Man and in Mosquito. microbenotes.com [online]. 2022-01-15 [cit. 2025-02-02]. Dostupné online. (anglicky)
- ↑ LANGHI, Dante M.; ORLANDO BORDIN, José. Duffy blood group and malaria. Hematology. 2006-10-01, roč. 11, čís. 5–6, s. 389–398. PMID: 17607593. Dostupné online [cit. 2025-02-03]. doi:10.1080/10245330500469841. PMID 17607593.
- ↑ MERCEREAU-PUIJALON, O.; MÉNARD, D. Plasmodium vivax and the Duffy antigen: A paradigm revisited. Transfusion Clinique et Biologique. 2010-09-01, roč. 17, čís. "Role of blood group antigens and associated molecules in red cell biology: from molecular approach to clinical applications" organized by Institut National de la Transfusion Sanguine, September 15th to 17th 2010, s. 176–183. Dostupné online [cit. 2025-02-03]. ISSN 1246-7820. doi:10.1016/j.tracli.2010.06.005.
- ↑ Plasmodium vivax - an overview | ScienceDirect Topics. www.sciencedirect.com [online]. [cit. 2025-02-02]. Dostupné online.
- ↑ LOY, Dorothy E.; LIU, Weimin; LI, Yingying. Out of Africa: origins and evolution of the human malaria parasites Plasmodium falciparum and Plasmodium vivax. International Journal for Parasitology. 2017-02-01, roč. 47, čís. Molecular Approaches to Malaria 2016 (MAM2016), s. 87–97. Dostupné online [cit. 2025-02-03]. ISSN 0020-7519. doi:10.1016/j.ijpara.2016.05.008. PMID 27381764.
Externí odkazy
Obrázky, zvuky či videa k tématu Plasmodium vivax na Wikimedia Commons